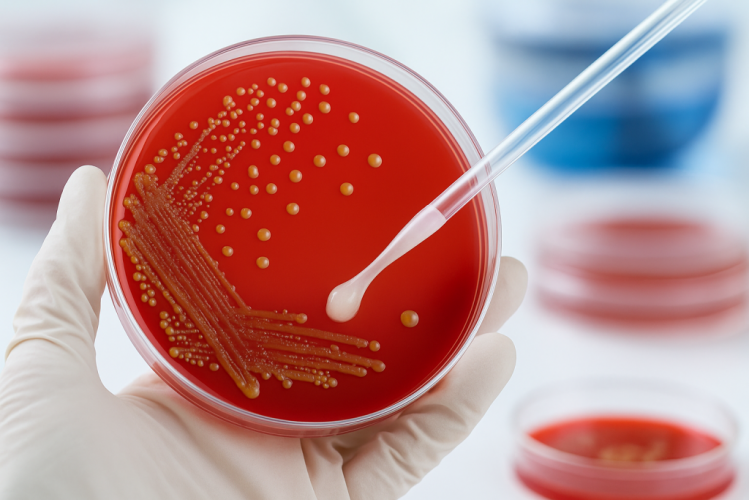
Бактериологический посев спермы

–ó–į—Ź–≤–ļ–į –Ņ—Ä–ł–Ĺ—Ź—ā–į

–í–į—Ä–ł–ļ–ĺ—Ü–Ķ–Ľ–Ķ: –Ņ—Ä–ł—á–ł–Ĺ—č –ł –ĺ—Ā–ĺ–Ī–Ķ–Ĺ–Ĺ–ĺ—Ā—ā–ł –∑–į–Ī–ĺ–Ľ–Ķ–≤–į–Ĺ–ł—Ź
–í–į—Ä–ł–ļ–ĺ—Ü–Ķ–Ľ–Ķ ‚ÄĒ —ć—ā–ĺ –≤–į—Ä–ł–ļ–ĺ–∑–Ĺ–ĺ–Ķ —Ä–į—Ā—ą–ł—Ä–Ķ–Ĺ–ł–Ķ –≤–Ķ–Ĺ —Ā–Ķ–ľ–Ķ–Ĺ–Ĺ–ĺ–≥–ĺ –ļ–į–Ĺ–į—ā–ł–ļ–į, —Ā–ĺ–Ņ—Ä–ĺ–≤–ĺ–∂–ī–į—é—Č–Ķ–Ķ—Ā—Ź –Ĺ–į—Ä—É—ą–Ķ–Ĺ–ł–Ķ–ľ –ĺ—ā—ā–ĺ–ļ–į –ļ—Ä–ĺ–≤–ł –ĺ—ā —Ź–ł—á–ļ–į. –Ď–ĺ–Ľ–Ķ–∑–Ĺ—Ć —á–į—Č–Ķ –≤—Ā—ā—Ä–Ķ—á–į–Ķ—ā—Ā—Ź —É –ľ—É–∂—á–ł–Ĺ —Ä–Ķ–Ņ—Ä–ĺ–ī—É–ļ—ā–ł–≤–Ĺ–ĺ–≥–ĺ –≤–ĺ–∑—Ä–į—Ā—ā–į –ł –ľ–ĺ–∂–Ķ—ā –Ņ—Ä–ł–≤–ĺ–ī–ł—ā—Ć –ļ –Ī–Ķ—Ā–Ņ–Ľ–ĺ–ī–ł—é –Ņ—Ä–ł –ĺ—ā—Ā—É—ā—Ā—ā–≤–ł–ł –Ľ–Ķ—á–Ķ–Ĺ–ł—Ź. –í–Ķ–Ĺ—č —ā–Ķ—Ä—Ź—é—ā —ć–Ľ–į—Ā—ā–ł—á–Ĺ–ĺ—Ā—ā—Ć, –ļ—Ä–ĺ–≤–ĺ—ā–ĺ–ļ –∑–į–ľ–Ķ–ī–Ľ—Ź–Ķ—ā—Ā—Ź, –ł –≤–ĺ–∑–Ĺ–ł–ļ–į–Ķ—ā –∑–į—Ā—ā–ĺ–Ļ –ļ—Ä–ĺ–≤–ł, —á—ā–ĺ —Ā–ĺ –≤—Ä–Ķ–ľ–Ķ–Ĺ–Ķ–ľ –Ņ—Ä–ĺ–≤–ĺ—Ü–ł—Ä—É–Ķ—ā –Ņ–Ķ—Ä–Ķ–≥—Ä–Ķ–≤ —ā–ļ–į–Ĺ–Ķ–Ļ —Ź–ł—á–ļ–į. –ß–į—Č–Ķ –≤—Ā–Ķ–≥–ĺ –≤–į—Ä–ł–ļ–ĺ—Ü–Ķ–Ľ–Ķ –ī–ł–į–≥–Ĺ–ĺ—Ā—ā–ł—Ä—É–Ķ—ā—Ā—Ź —Ā –Ľ–Ķ–≤–ĺ–Ļ —Ā—ā–ĺ—Ä–ĺ–Ĺ—č, –Ĺ–ĺ –≤–ĺ–∑–ľ–ĺ–∂–Ĺ–ĺ –ł –ī–≤—É—Ā—ā–ĺ—Ä–ĺ–Ĺ–Ĺ–Ķ–Ķ –Ņ–ĺ—Ä–į–∂–Ķ–Ĺ–ł–Ķ. –Ě–į —Ä–į–Ĺ–Ĺ–ł—Ö —Ā—ā–į–ī–ł—Ź—Ö –Ī–ĺ–Ľ–Ķ–∑–Ĺ—Ć –Ņ—Ä–ĺ—ā–Ķ–ļ–į–Ķ—ā –Ī–Ķ—Ā—Ā–ł–ľ–Ņ—ā–ĺ–ľ–Ĺ–ĺ, –Ĺ–ĺ —Ā–ĺ –≤—Ä–Ķ–ľ–Ķ–Ĺ–Ķ–ľ –Ņ–ĺ—Ź–≤–Ľ—Ź—é—ā—Ā—Ź –Ī–ĺ–Ľ–ł –ł —ā—Ź–∂–Ķ—Ā—ā—Ć –≤ –Ņ–į—Ö—É.
–ü—Ä–ł—á–ł–Ĺ–į–ľ–ł –≤–į—Ä–ł–ļ–ĺ—Ü–Ķ–Ľ–Ķ –ľ–ĺ–≥—É—ā –Ī—č—ā—Ć –≤—Ä–ĺ–∂–ī—Ď–Ĺ–Ĺ—č–Ķ –ĺ—Ā–ĺ–Ī–Ķ–Ĺ–Ĺ–ĺ—Ā—ā–ł –≤–Ķ–Ĺ–ĺ–∑–Ĺ–ĺ–Ļ —Ā–ł—Ā—ā–Ķ–ľ—č –ł –Ņ–ĺ–≤—č—ą–Ķ–Ĺ–Ĺ–ĺ–Ķ –ī–į–≤–Ľ–Ķ–Ĺ–ł–Ķ –≤ –≤–Ķ–Ĺ–į—Ö –ľ–į–Ľ–ĺ–≥–ĺ —ā–į–∑–į. –ö —Ä–į–∑–≤–ł—ā–ł—é –Ī–ĺ–Ľ–Ķ–∑–Ĺ–ł –Ņ—Ä–Ķ–ī—Ä–į—Ā–Ņ–ĺ–Ľ–į–≥–į—é—ā —Ą–ł–∑–ł—á–Ķ—Ā–ļ–ł–Ķ –Ņ–Ķ—Ä–Ķ–≥—Ä—É–∑–ļ–ł, —Ö—Ä–ĺ–Ĺ–ł—á–Ķ—Ā–ļ–ł–Ķ –∑–į–Ņ–ĺ—Ä—č, –ľ–į–Ľ–ĺ–Ņ–ĺ–ī–≤–ł–∂–Ĺ—č–Ļ –ĺ–Ī—Ä–į–∑ –∂–ł–∑–Ĺ–ł –ł –ī–Ľ–ł—ā–Ķ–Ľ—Ć–Ĺ–ĺ–Ķ –Ņ–ĺ–Ľ–ĺ–≤–ĺ–Ķ –≤–ĺ–∑–ī–Ķ—Ä–∂–į–Ĺ–ł–Ķ. –°—Ä–Ķ–ī–ł —Ą–į–ļ—ā–ĺ—Ä–ĺ–≤ —Ä–ł—Ā–ļ–į –≤—č–ī–Ķ–Ľ—Ź—é—ā:
‚ÄĘ –Ě–į—Ā–Ľ–Ķ–ī—Ā—ā–≤–Ķ–Ĺ–Ĺ—É—é —Ā–Ľ–į–Ī–ĺ—Ā—ā—Ć –≤–Ķ–Ĺ–ĺ–∑–Ĺ—č—Ö —Ā—ā–Ķ–Ĺ–ĺ–ļ
‚ÄĘ –Ě–į—Ä—É—ą–Ķ–Ĺ–ł–Ķ –≤–Ķ–Ĺ–ĺ–∑–Ĺ—č—Ö –ļ–Ľ–į–Ņ–į–Ĺ–ĺ–≤
‚ÄĘ –ß–į—Ā—ā—č–Ķ —Ą–ł–∑–ł—á–Ķ—Ā–ļ–ł–Ķ –Ĺ–į–≥—Ä—É–∑–ļ–ł –ł –Ņ–ĺ–ī—ä—Ď–ľ —ā—Ź–∂–Ķ—Ā—ā–Ķ–Ļ
–Ē–ł–į–≥–Ĺ–ĺ—Ā—ā–ł–ļ–į –∑–į–Ī–ĺ–Ľ–Ķ–≤–į–Ĺ–ł—Ź –ĺ—Ā–Ĺ–ĺ–≤—č–≤–į–Ķ—ā—Ā—Ź –Ĺ–į –ĺ—Ā–ľ–ĺ—ā—Ä–Ķ —É—Ä–ĺ–Ľ–ĺ–≥–į, –Ņ–į–Ľ—Ć–Ņ–į—Ü–ł–ł –ł –ł–Ĺ—Ā—ā—Ä—É–ľ–Ķ–Ĺ—ā–į–Ľ—Ć–Ĺ—č—Ö –ľ–Ķ—ā–ĺ–ī–į—Ö ‚ÄĒ –£–ó–ė –ľ–ĺ—ą–ĺ–Ĺ–ļ–ł –ł –ī–ĺ–Ņ–Ņ–Ľ–Ķ—Ä–ĺ–≥—Ä–į—Ą–ł–ł. –í—Ä–į—á –ĺ–Ņ—Ä–Ķ–ī–Ķ–Ľ—Ź–Ķ—ā —Ā—ā–Ķ–Ņ–Ķ–Ĺ—Ć –≤–į—Ä–ł–ļ–ĺ—Ü–Ķ–Ľ–Ķ, –ĺ—Ü–Ķ–Ĺ–ł–≤–į–Ķ—ā —Ā–ĺ—Ā—ā–ĺ—Ź–Ĺ–ł–Ķ –ļ—Ä–ĺ–≤–ĺ—ā–ĺ–ļ–į –ł –≤—č–Ī–ł—Ä–į–Ķ—ā —ā–į–ļ—ā–ł–ļ—É –Ľ–Ķ—á–Ķ–Ĺ–ł—Ź. –°–≤–ĺ–Ķ–≤—Ä–Ķ–ľ–Ķ–Ĺ–Ĺ–ĺ–Ķ –ĺ–Ī—Ä–į—Č–Ķ–Ĺ–ł–Ķ –ļ —Ā–Ņ–Ķ—Ü–ł–į–Ľ–ł—Ā—ā—É –Ņ–ĺ–∑–≤–ĺ–Ľ—Ź–Ķ—ā –ł–∑–Ī–Ķ–∂–į—ā—Ć –ĺ—Ā–Ľ–ĺ–∂–Ĺ–Ķ–Ĺ–ł–Ļ, —ā–į–ļ–ł—Ö –ļ–į–ļ –į—ā—Ä–ĺ—Ą–ł—Ź —Ź–ł—á–ļ–į –ł–Ľ–ł –Ī–Ķ—Ā–Ņ–Ľ–ĺ–ī–ł–Ķ.
–õ–Ķ—á–Ķ–Ĺ–ł–Ķ –Ņ–ĺ–ī–Ī–ł—Ä–į–Ķ—ā—Ā—Ź –ł–Ĺ–ī–ł–≤–ł–ī—É–į–Ľ—Ć–Ĺ–ĺ —Ā —É—á—Ď—ā–ĺ–ľ –≤–ĺ–∑—Ä–į—Ā—ā–į, —Ā–ł–ľ–Ņ—ā–ĺ–ľ–ĺ–≤ –ł –Ņ–Ľ–į–Ĺ–ĺ–≤ –Ņ–į—Ü–ł–Ķ–Ĺ—ā–į –Ĺ–į –Ī—É–ī—É—Č–Ķ–Ķ –ĺ—ā—Ü–ĺ–≤—Ā—ā–≤–ĺ. –Ě–į —Ä–į–Ĺ–Ĺ–ł—Ö —Ā—ā–į–ī–ł—Ź—Ö –Ņ—Ä–ł–ľ–Ķ–Ĺ—Ź—é—ā –ļ–ĺ–Ĺ—Ā–Ķ—Ä–≤–į—ā–ł–≤–Ĺ—č–Ķ –ľ–Ķ—ā–ĺ–ī—č, –į –Ņ—Ä–ł –≤—č—Ä–į–∂–Ķ–Ĺ–Ĺ—č—Ö –ł–∑–ľ–Ķ–Ĺ–Ķ–Ĺ–ł—Ź—Ö ‚ÄĒ —Ö–ł—Ä—É—Ä–≥–ł—á–Ķ—Ā–ļ–ĺ–Ķ –≤–ľ–Ķ—ą–į—ā–Ķ–Ľ—Ć—Ā—ā–≤–ĺ.
–°–ł–ľ–Ņ—ā–ĺ–ľ—č –ł —Ā—ā–į–ī–ł–ł –≤–į—Ä–ł–ļ–ĺ—Ü–Ķ–Ľ–Ķ
–ó–į–Ī–ĺ–Ľ–Ķ–≤–į–Ĺ–ł–Ķ –Ņ—Ä–ĺ—Ö–ĺ–ī–ł—ā –Ĺ–Ķ—Ā–ļ–ĺ–Ľ—Ć–ļ–ĺ —Ā—ā–į–ī–ł–Ļ ‚ÄĒ –ĺ—ā —Ā–ļ—Ä—č—ā–ĺ–Ļ –ī–ĺ –≤—č—Ä–į–∂–Ķ–Ĺ–Ĺ–ĺ–Ļ —Ą–ĺ—Ä–ľ—č —Ā –≤–ł–ī–ł–ľ—č–ľ —Ä–į—Ā—ą–ł—Ä–Ķ–Ĺ–ł–Ķ–ľ –≤–Ķ–Ĺ. –Ě–į –Ņ–Ķ—Ä–≤–ĺ–Ļ —Ā—ā–į–ī–ł–ł –Ņ—Ä–ł–∑–Ĺ–į–ļ–ł –ľ–ł–Ĺ–ł–ľ–į–Ľ—Ć–Ĺ—č, –Ņ–į—Ü–ł–Ķ–Ĺ—ā –ľ–ĺ–∂–Ķ—ā –ĺ—Č—É—Č–į—ā—Ć –Ľ–ł—ą—Ć –Ľ—Ď–≥–ļ–ł–Ļ –ī–ł—Ā–ļ–ĺ–ľ—Ą–ĺ—Ä—ā –Ņ—Ä–ł –Ĺ–į–≥—Ä—É–∑–ļ–Ķ. –Ě–į –≤—ā–ĺ—Ä–ĺ–Ļ ‚ÄĒ –≤–Ķ–Ĺ—č —Ā—ā–į–Ĺ–ĺ–≤—Ź—ā—Ā—Ź –∑–į–ľ–Ķ—ā–Ĺ–Ķ–Ķ, –Ņ–ĺ—Ź–≤–Ľ—Ź–Ķ—ā—Ā—Ź –Ī–ĺ–Ľ—Ć –≤ –ľ–ĺ—ą–ĺ–Ĺ–ļ–Ķ, –ĺ—Ā–ĺ–Ī–Ķ–Ĺ–Ĺ–ĺ –Ņ—Ä–ł —Ā—ā–ĺ—Ź–Ĺ–ł–ł –ł–Ľ–ł —Ą–ł–∑–ł—á–Ķ—Ā–ļ–ĺ–Ļ –į–ļ—ā–ł–≤–Ĺ–ĺ—Ā—ā–ł. –Ě–į —ā—Ä–Ķ—ā—Ć–Ķ–Ļ —Ā—ā–į–ī–ł–ł –≤–Ķ–Ĺ—č —Ä–į—Ā—ą–ł—Ä—Ź—é—ā—Ā—Ź –∑–Ĺ–į—á–ł—ā–Ķ–Ľ—Ć–Ĺ–ĺ, –ľ–ĺ—ą–ĺ–Ĺ–ļ–į –ī–Ķ—Ą–ĺ—Ä–ľ–ł—Ä—É–Ķ—ā—Ā—Ź, –į —Ź–ł—á–ļ–ĺ –ľ–ĺ–∂–Ķ—ā —É–ľ–Ķ–Ĺ—Ć—ą–į—ā—Ć—Ā—Ź –≤ —Ä–į–∑–ľ–Ķ—Ä–Ķ. –≠—ā–ł —Ā–ł–ľ–Ņ—ā–ĺ–ľ—č —ā—Ä–Ķ–Ī—É—é—ā –Ĺ–Ķ–ľ–Ķ–ī–Ľ–Ķ–Ĺ–Ĺ–ĺ–≥–ĺ –ĺ–Ī—Ä–į—Č–Ķ–Ĺ–ł—Ź –ļ —É—Ä–ĺ–Ľ–ĺ–≥—É.
–ö–Ľ–ł–Ĺ–ł—á–Ķ—Ā–ļ–ł–Ķ –Ņ—Ä–ĺ—Ź–≤–Ľ–Ķ–Ĺ–ł—Ź –≤–į—Ä–ł–ļ–ĺ—Ü–Ķ–Ľ–Ķ –ľ–ĺ–≥—É—ā —É—Ā–ł–Ľ–ł–≤–į—ā—Ć—Ā—Ź –Ņ—Ä–ł –Ņ–ĺ–≤—č—ą–Ķ–Ĺ–ł–ł —ā–Ķ–ľ–Ņ–Ķ—Ä–į—ā—É—Ä—č –ł–Ľ–ł –ī–Ľ–ł—ā–Ķ–Ľ—Ć–Ĺ–ĺ–ľ –Ĺ–į—Ö–ĺ–∂–ī–Ķ–Ĺ–ł–ł –≤ –≤–Ķ—Ä—ā–ł–ļ–į–Ľ—Ć–Ĺ–ĺ–ľ –Ņ–ĺ–Ľ–ĺ–∂–Ķ–Ĺ–ł–ł. –Ę–į–ļ–∂–Ķ –Ņ–į—Ü–ł–Ķ–Ĺ—ā—č –ĺ—ā–ľ–Ķ—á–į—é—ā –ĺ—Č—É—Č–Ķ–Ĺ–ł–Ķ –∂–∂–Ķ–Ĺ–ł—Ź, —ā—Ź–∂–Ķ—Ā—ā–ł –ł —ā—Ź–Ĺ—É—Č–ł—Ö –Ī–ĺ–Ľ–Ķ–Ļ, –ļ–ĺ—ā–ĺ—Ä—č–Ķ –ł—Ā—á–Ķ–∑–į—é—ā –≤ –Ņ–ĺ–Ľ–ĺ–∂–Ķ–Ĺ–ł–ł –Ľ—Ď–∂–į.
‚ÄĘ –Ď–ĺ–Ľ—Ć —É—Ā–ł–Ľ–ł–≤–į–Ķ—ā—Ā—Ź –Ņ—Ä–ł –Ĺ–į–≥—Ä—É–∑–ļ–Ķ
‚ÄĘ –Ě–į—Ä—É—ą–į–Ķ—ā—Ā—Ź —ā–Ķ—Ä–ľ–ĺ—Ä–Ķ–≥—É–Ľ—Ź—Ü–ł—Ź —Ź–ł—á–Ķ–ļ
‚ÄĘ –í–ĺ–∑–ľ–ĺ–∂–Ĺ–į –į—Ā–ł–ľ–ľ–Ķ—ā—Ä–ł—Ź –ľ–ĺ—ą–ĺ–Ĺ–ļ–ł
–Ē–ł–į–≥–Ĺ–ĺ–∑ —Ā—ā–į–≤–ł—ā—Ā—Ź –Ĺ–į –ĺ—Ā–Ĺ–ĺ–≤–į–Ĺ–ł–ł –ĺ—Ā–ľ–ĺ—ā—Ä–į –ł —É–Ľ—Ć—ā—Ä–į–∑–≤—É–ļ–ĺ–≤–ĺ–≥–ĺ –ł—Ā—Ā–Ľ–Ķ–ī–ĺ–≤–į–Ĺ–ł—Ź —Ā –Ņ—Ä–ĺ–Ī–ĺ–Ļ –í–į–Ľ—Ć—Ā–į–Ľ—Ć–≤—č. –≠—ā–ĺ—ā —ā–Ķ—Ā—ā –Ņ–ĺ–∑–≤–ĺ–Ľ—Ź–Ķ—ā –ĺ–Ņ—Ä–Ķ–ī–Ķ–Ľ–ł—ā—Ć —Ā—ā–Ķ–Ņ–Ķ–Ĺ—Ć –Ĺ–į—Ä—É—ą–Ķ–Ĺ–ł—Ź –ļ—Ä–ĺ–≤–ĺ—ā–ĺ–ļ–į –ł —Ā—ā–Ķ–Ņ–Ķ–Ĺ—Ć –∑–į–Ī–ĺ–Ľ–Ķ–≤–į–Ĺ–ł—Ź. –ß–Ķ–ľ –≤—č—ą–Ķ —Ā—ā–į–ī–ł—Ź, —ā–Ķ–ľ –Ī–ĺ–Ľ—Ć—ą–Ķ —Ä–ł—Ā–ļ –Ĺ–į—Ä—É—ą–Ķ–Ĺ–ł—Ź —Ā–Ņ–Ķ—Ä–ľ–į—ā–ĺ–≥–Ķ–Ĺ–Ķ–∑–į –ł —Ā–Ĺ–ł–∂–Ķ–Ĺ–ł—Ź –ľ—É–∂—Ā–ļ–ĺ–Ļ —Ą–Ķ—Ä—ā–ł–Ľ—Ć–Ĺ–ĺ—Ā—ā–ł.
–í–į–∂–Ĺ–ĺ –Ĺ–Ķ –ł–≥–Ĺ–ĺ—Ä–ł—Ä–ĺ–≤–į—ā—Ć —Ā–ł–ľ–Ņ—ā–ĺ–ľ—č, —ā–į–ļ –ļ–į–ļ –Ņ—Ä–ł –Ņ—Ä–ĺ–≥—Ä–Ķ—Ā—Ā–ł—Ä–ĺ–≤–į–Ĺ–ł–ł –Ī–ĺ–Ľ–Ķ–∑–Ĺ–ł –ľ–ĺ–∂–Ķ—ā —Ä–į–∑–≤–ł—ā—Ć—Ā—Ź –į—ā—Ä–ĺ—Ą–ł—Ź —ā–ļ–į–Ĺ–Ķ–Ļ –ł –Ī–Ķ—Ā–Ņ–Ľ–ĺ–ī–ł–Ķ. –†–į–Ĺ–Ĺ—Ź—Ź –ī–ł–į–≥–Ĺ–ĺ—Ā—ā–ł–ļ–į –Ņ–ĺ–∑–≤–ĺ–Ľ—Ź–Ķ—ā –Ņ—Ä–ĺ–≤–Ķ—Ā—ā–ł –Ľ–Ķ—á–Ķ–Ĺ–ł–Ķ —Ā –ľ–ł–Ĺ–ł–ľ–į–Ľ—Ć–Ĺ—č–ľ —Ä–ł—Ā–ļ–ĺ–ľ –ĺ—Ā–Ľ–ĺ–∂–Ĺ–Ķ–Ĺ–ł–Ļ.

–Ē–ł–į–≥–Ĺ–ĺ—Ā—ā–ł–ļ–į –≤–į—Ä–ł–ļ–ĺ—Ü–Ķ–Ľ–Ķ
–°–ĺ–≤—Ä–Ķ–ľ–Ķ–Ĺ–Ĺ—č–Ķ –ľ–Ķ—ā–ĺ–ī—č –ī–ł–į–≥–Ĺ–ĺ—Ā—ā–ł–ļ–ł –Ņ–ĺ–∑–≤–ĺ–Ľ—Ź—é—ā —ā–ĺ—á–Ĺ–ĺ –ĺ–Ņ—Ä–Ķ–ī–Ķ–Ľ–ł—ā—Ć —Ā—ā–į–ī–ł—é –∑–į–Ī–ĺ–Ľ–Ķ–≤–į–Ĺ–ł—Ź –ł –Ņ–ĺ–ī–ĺ–Ī—Ä–į—ā—Ć –ĺ–Ņ—ā–ł–ľ–į–Ľ—Ć–Ĺ—č–Ļ –ľ–Ķ—ā–ĺ–ī –Ľ–Ķ—á–Ķ–Ĺ–ł—Ź. –£—Ä–ĺ–Ľ–ĺ–≥ –Ņ—Ä–ĺ–≤–ĺ–ī–ł—ā —Ą–ł–∑–ł–ļ–į–Ľ—Ć–Ĺ—č–Ļ –ĺ—Ā–ľ–ĺ—ā—Ä, –Ņ–į–Ľ—Ć–Ņ–į—Ü–ł—é –ł –Ĺ–į–∑–Ĺ–į—á–į–Ķ—ā –£–ó–ė —Ā –ī–ĺ–Ņ–Ņ–Ľ–Ķ—Ä–ĺ–≥—Ä–į—Ą–ł–Ķ–Ļ –ī–Ľ—Ź –ĺ—Ü–Ķ–Ĺ–ļ–ł —Ā–ĺ—Ā—ā–ĺ—Ź–Ĺ–ł—Ź –≤–Ķ–Ĺ. –≠—ā–ĺ—ā –ľ–Ķ—ā–ĺ–ī –Ņ–ĺ–ľ–ĺ–≥–į–Ķ—ā –≤–ł–∑—É–į–Ľ–ł–∑–ł—Ä–ĺ–≤–į—ā—Ć –ĺ–Ī—Ä–į—ā–Ĺ—č–Ļ —ā–ĺ–ļ –ļ—Ä–ĺ–≤–ł –ł –≤—č—Ź–≤–ł—ā—Ć –ī–į–∂–Ķ –ľ–ł–Ĺ–ł–ľ–į–Ľ—Ć–Ĺ—č–Ķ –ł–∑–ľ–Ķ–Ĺ–Ķ–Ĺ–ł—Ź –Ĺ–į —Ä–į–Ĺ–Ĺ–Ķ–Ļ —Ā—ā–į–ī–ł–ł.
–Ē–ĺ–Ņ–ĺ–Ľ–Ĺ–ł—ā–Ķ–Ľ—Ć–Ĺ–ĺ –Ĺ–į–∑–Ĺ–į—á–į—é—ā—Ā—Ź –Ľ–į–Ī–ĺ—Ä–į—ā–ĺ—Ä–Ĺ—č–Ķ –ł—Ā—Ā–Ľ–Ķ–ī–ĺ–≤–į–Ĺ–ł—Ź –ł —Ā–Ņ–Ķ—Ä–ľ–ĺ–≥—Ä–į–ľ–ľ–į –ī–Ľ—Ź –ĺ—Ü–Ķ–Ĺ–ļ–ł —Ą–Ķ—Ä—ā–ł–Ľ—Ć–Ĺ–ĺ—Ā—ā–ł –ľ—É–∂—á–ł–Ĺ—č. –í –Ĺ–Ķ–ļ–ĺ—ā–ĺ—Ä—č—Ö —Ā–Ľ—É—á–į—Ź—Ö –Ņ—Ä–ĺ–≤–ĺ–ī–ł—ā—Ā—Ź —ā–Ķ—Ä–ľ–ĺ–≥—Ä–į—Ą–ł—Ź –ł–Ľ–ł —Ą–Ľ–Ķ–Ī–ĺ–≥—Ä–į—Ą–ł—Ź –ī–Ľ—Ź —É—ā–ĺ—á–Ĺ–Ķ–Ĺ–ł—Ź —Ö–į—Ä–į–ļ—ā–Ķ—Ä–į –Ĺ–į—Ä—É—ą–Ķ–Ĺ–ł—Ź.
‚ÄĘ –£–ó–ė –ľ–ĺ—ą–ĺ–Ĺ–ļ–ł —Ā –ī–ĺ–Ņ–Ņ–Ľ–Ķ—Ä–ĺ–ľ
‚ÄĘ –ź–Ĺ–į–Ľ–ł–∑ —Ā–Ņ–Ķ—Ä–ľ—č
‚ÄĘ –ě—Ā–ľ–ĺ—ā—Ä —É—Ä–ĺ–Ľ–ĺ–≥–į –ł –Ņ—Ä–ĺ–Ī–į –í–į–Ľ—Ć—Ā–į–Ľ—Ć–≤—č
–ö–ĺ–ľ–Ņ–Ľ–Ķ–ļ—Ā–Ĺ–ĺ–Ķ –ĺ–Ī—Ā–Ľ–Ķ–ī–ĺ–≤–į–Ĺ–ł–Ķ –Ņ–ĺ–∑–≤–ĺ–Ľ—Ź–Ķ—ā –ł—Ā–ļ–Ľ—é—á–ł—ā—Ć –ī—Ä—É–≥–ł–Ķ –∑–į–Ī–ĺ–Ľ–Ķ–≤–į–Ĺ–ł—Ź —Ā –Ņ–ĺ—Ö–ĺ–∂–ł–ľ–ł —Ā–ł–ľ–Ņ—ā–ĺ–ľ–į–ľ–ł, –Ĺ–į–Ņ—Ä–ł–ľ–Ķ—Ä –≥–ł–ī—Ä–ĺ—Ü–Ķ–Ľ–Ķ –ł–Ľ–ł –ĺ—Ä—Ö–ł—ā. –Ě–į –ĺ—Ā–Ĺ–ĺ–≤–Ķ –Ņ–ĺ–Ľ—É—á–Ķ–Ĺ–Ĺ—č—Ö –ī–į–Ĺ–Ĺ—č—Ö –≤—Ä–į—á —Ä–į–∑—Ä–į–Ī–į—ā—č–≤–į–Ķ—ā –Ņ–Ķ—Ä—Ā–ĺ–Ĺ–į–Ľ—Ć–Ĺ—č–Ļ –Ņ–Ľ–į–Ĺ —ā–Ķ—Ä–į–Ņ–ł–ł.
–ď–Ľ–į–≤–Ĺ–į—Ź —Ü–Ķ–Ľ—Ć –ī–ł–į–≥–Ĺ–ĺ—Ā—ā–ł–ļ–ł ‚ÄĒ –ĺ–Ņ—Ä–Ķ–ī–Ķ–Ľ–ł—ā—Ć —Ā—ā–Ķ–Ņ–Ķ–Ĺ—Ć –≤–Ķ–Ĺ–ĺ–∑–Ĺ–ĺ–≥–ĺ —Ä–į—Ā—ą–ł—Ä–Ķ–Ĺ–ł—Ź –ł –Ņ—Ä–Ķ–ī–ĺ—ā–≤—Ä–į—ā–ł—ā—Ć –ĺ—Ā–Ľ–ĺ–∂–Ĺ–Ķ–Ĺ–ł—Ź, –≤–ļ–Ľ—é—á–į—Ź –į—ā—Ä–ĺ—Ą–ł—é –ł —Ā–Ĺ–ł–∂–Ķ–Ĺ–ł–Ķ —Ā–Ņ–Ķ—Ä–ľ–į—ā–ĺ–≥–Ķ–Ĺ–Ķ–∑–į.
–ö–ĺ–Ĺ—Ā–Ķ—Ä–≤–į—ā–ł–≤–Ĺ–ĺ–Ķ –Ľ–Ķ—á–Ķ–Ĺ–ł–Ķ –Ĺ–į —Ä–į–Ĺ–Ĺ–ł—Ö —Ā—ā–į–ī–ł—Ź—Ö
–Ě–į –Ĺ–į—á–į–Ľ—Ć–Ĺ—č—Ö —Ā—ā–į–ī–ł—Ź—Ö –≤–į—Ä–ł–ļ–ĺ—Ü–Ķ–Ľ–Ķ –ľ–ĺ–∂–Ķ—ā –Ī—č—ā—Ć –Ĺ–į–∑–Ĺ–į—á–Ķ–Ĺ–ĺ –ļ–ĺ–Ĺ—Ā–Ķ—Ä–≤–į—ā–ł–≤–Ĺ–ĺ–Ķ –Ľ–Ķ—á–Ķ–Ĺ–ł–Ķ, –Ĺ–į–Ņ—Ä–į–≤–Ľ–Ķ–Ĺ–Ĺ–ĺ–Ķ –Ĺ–į —É–Ľ—É—á—ą–Ķ–Ĺ–ł–Ķ –≤–Ķ–Ĺ–ĺ–∑–Ĺ–ĺ–≥–ĺ –ĺ—ā—ā–ĺ–ļ–į –ł —É–ļ—Ä–Ķ–Ņ–Ľ–Ķ–Ĺ–ł–Ķ —Ā–ĺ—Ā—É–ī–ł—Ā—ā–ĺ–Ļ —Ā—ā–Ķ–Ĺ–ļ–ł. –ü—Ä–ł–ľ–Ķ–Ĺ—Ź—é—ā—Ā—Ź –Ņ—Ä–Ķ–Ņ–į—Ä–į—ā—č, –Ĺ–ĺ—Ä–ľ–į–Ľ–ł–∑—É—é—Č–ł–Ķ –ļ—Ä–ĺ–≤–ĺ–ĺ–Ī—Ä–į—Č–Ķ–Ĺ–ł–Ķ, –į —ā–į–ļ–∂–Ķ –≤–ł—ā–į–ľ–ł–Ĺ—č –ł –į–Ĺ—ā–ł–ĺ–ļ—Ā–ł–ī–į–Ĺ—ā—č. –í—Ä–į—á –ľ–ĺ–∂–Ķ—ā —Ä–Ķ–ļ–ĺ–ľ–Ķ–Ĺ–ī–ĺ–≤–į—ā—Ć –ļ–ĺ—Ä—Ä–Ķ–ļ—Ü–ł—é –ĺ–Ī—Ä–į–∑–į –∂–ł–∑–Ĺ–ł ‚ÄĒ —É–ľ–Ķ–Ĺ—Ć—ą–Ķ–Ĺ–ł–Ķ —Ą–ł–∑–ł—á–Ķ—Ā–ļ–ł—Ö –Ĺ–į–≥—Ä—É–∑–ĺ–ļ, –Ĺ–ĺ—Ä–ľ–į–Ľ–ł–∑–į—Ü–ł—é –≤–Ķ—Ā–į –ł —Ä–Ķ–≥—É–Ľ—Ź—Ä–Ĺ—É—é –Ņ–ĺ–Ľ–ĺ–≤—É—é –į–ļ—ā–ł–≤–Ĺ–ĺ—Ā—ā—Ć.
–ü–ĺ–Ľ–Ķ–∑–Ĺ–ĺ –Ĺ–ĺ—Ā–ł—ā—Ć –Ņ–ĺ–ī–ī–Ķ—Ä–∂–ł–≤–į—é—Č–Ķ–Ķ –Ī–Ķ–Ľ—Ć—Ď, –ļ–ĺ—ā–ĺ—Ä–ĺ–Ķ —Ā–Ĺ–ł–∂–į–Ķ—ā –ī–į–≤–Ľ–Ķ–Ĺ–ł–Ķ –Ĺ–į —Ź–ł—á–ļ–ł –ł —É–Ľ—É—á—ą–į–Ķ—ā —Ü–ł—Ä–ļ—É–Ľ—Ź—Ü–ł—é –ļ—Ä–ĺ–≤–ł. –Ę–į–ļ–∂–Ķ –Ņ—Ä–ł–ľ–Ķ–Ĺ—Ź—é—ā—Ā—Ź —Ą–ł–∑–ł–ĺ—ā–Ķ—Ä–į–Ņ–Ķ–≤—ā–ł—á–Ķ—Ā–ļ–ł–Ķ –ľ–Ķ—ā–ĺ–ī—č, –ľ–į—Ā—Ā–į–∂ –ł –Ľ–Ķ—á–Ķ–Ī–Ĺ–į—Ź –≥–ł–ľ–Ĺ–į—Ā—ā–ł–ļ–į –ī–Ľ—Ź –Ņ—Ä–ĺ—Ą–ł–Ľ–į–ļ—ā–ł–ļ–ł –∑–į—Ā—ā–ĺ—Ź –ļ—Ä–ĺ–≤–ł.
–≠—ā–ł –ľ–Ķ—Ä—č —ć—Ą—Ą–Ķ–ļ—ā–ł–≤–Ĺ—č –Ņ—Ä–ł –Ņ–Ķ—Ä–≤–ĺ–Ļ —Ā—ā–Ķ–Ņ–Ķ–Ĺ–ł –∑–į–Ī–ĺ–Ľ–Ķ–≤–į–Ĺ–ł—Ź, –ļ–ĺ–≥–ī–į –Ĺ–Ķ—ā –≤—č—Ä–į–∂–Ķ–Ĺ–Ĺ–ĺ–≥–ĺ –Ĺ–į—Ä—É—ą–Ķ–Ĺ–ł—Ź —Ā–Ņ–Ķ—Ä–ľ–į—ā–ĺ–≥–Ķ–Ĺ–Ķ–∑–į. –ě–ī–Ĺ–į–ļ–ĺ –Ņ—Ä–ł –Ņ—Ä–ĺ–≥—Ä–Ķ—Ā—Ā–ł—Ä–ĺ–≤–į–Ĺ–ł–ł –Ī–ĺ–Ľ–Ķ–∑–Ĺ–ł –ļ–ĺ–Ĺ—Ā–Ķ—Ä–≤–į—ā–ł–≤–Ĺ—č–Ķ –ľ–Ķ—Ä—č —Ā—ā–į–Ĺ–ĺ–≤—Ź—ā—Ā—Ź –Ĺ–Ķ–ī–ĺ—Ā—ā–į—ā–ĺ—á–Ĺ—č–ľ–ł.
–í —ā–į–ļ–ł—Ö —Ā–Ľ—É—á–į—Ź—Ö –Ņ–į—Ü–ł–Ķ–Ĺ—ā—É –Ņ—Ä–Ķ–ī–Ľ–į–≥–į—é—ā—Ā—Ź —Ā–ĺ–≤—Ä–Ķ–ľ–Ķ–Ĺ–Ĺ—č–Ķ —Ö–ł—Ä—É—Ä–≥–ł—á–Ķ—Ā–ļ–ł–Ķ –ľ–Ķ—ā–ĺ–ī—č, –ļ–ĺ—ā–ĺ—Ä—č–Ķ –ĺ–Ī–Ķ—Ā–Ņ–Ķ—á–ł–≤–į—é—ā —Ā—ā–ĺ–Ļ–ļ–ł–Ļ —Ä–Ķ–∑—É–Ľ—Ć—ā–į—ā –ł –ľ–ł–Ĺ–ł–ľ–į–Ľ—Ć–Ĺ—č–Ļ —Ä–ł—Ā–ļ —Ä–Ķ—Ü–ł–ī–ł–≤–į.

–•–ł—Ä—É—Ä–≥–ł—á–Ķ—Ā–ļ–ĺ–Ķ –Ľ–Ķ—á–Ķ–Ĺ–ł–Ķ –≤–į—Ä–ł–ļ–ĺ—Ü–Ķ–Ľ–Ķ
–ě—Ā–Ĺ–ĺ–≤–Ĺ—č–ľ –ľ–Ķ—ā–ĺ–ī–ĺ–ľ –Ľ–Ķ—á–Ķ–Ĺ–ł—Ź —Ź–≤–Ľ—Ź–Ķ—ā—Ā—Ź –ĺ–Ņ–Ķ—Ä–į—Ü–ł—Ź, –Ĺ–į–Ņ—Ä–į–≤–Ľ–Ķ–Ĺ–Ĺ–į—Ź –Ĺ–į —É—Ā—ā—Ä–į–Ĺ–Ķ–Ĺ–ł–Ķ –ĺ–Ī—Ä–į—ā–Ĺ–ĺ–≥–ĺ —ā–ĺ–ļ–į –ļ—Ä–ĺ–≤–ł –Ņ–ĺ –Ņ–į—ā–ĺ–Ľ–ĺ–≥–ł—á–Ķ—Ā–ļ–ł–ľ –≤–Ķ–Ĺ–į–ľ. –ü—Ä–ł–ľ–Ķ–Ĺ—Ź—é—ā—Ā—Ź —Ä–į–∑–Ľ–ł—á–Ĺ—č–Ķ —ā–Ķ—Ö–Ĺ–ł–ļ–ł ‚ÄĒ –ľ–ł–ļ—Ä–ĺ—Ö–ł—Ä—É—Ä–≥–ł—á–Ķ—Ā–ļ–į—Ź –≤–į—Ä–ł–ļ–ĺ—Ü–Ķ–Ľ—ć–ļ—ā–ĺ–ľ–ł—Ź, –Ľ–į–Ņ–į—Ä–ĺ—Ā–ļ–ĺ–Ņ–ł—Ź –ł–Ľ–ł —ć–Ĺ–ī–ĺ–≤–į—Ā–ļ—É–Ľ—Ź—Ä–Ĺ–į—Ź —ć–ľ–Ī–ĺ–Ľ–ł–∑–į—Ü–ł—Ź. –í—č–Ī–ĺ—Ä –ľ–Ķ—ā–ĺ–ī–į –∑–į–≤–ł—Ā–ł—ā –ĺ—ā —Ā—ā–į–ī–ł–ł, –≤–ĺ–∑—Ä–į—Ā—ā–į –ł —Ā–ĺ—Ā—ā–ĺ—Ź–Ĺ–ł—Ź –∑–ī–ĺ—Ä–ĺ–≤—Ć—Ź –Ņ–į—Ü–ł–Ķ–Ĺ—ā–į.
–ú–ł–ļ—Ä–ĺ—Ö–ł—Ä—É—Ä–≥–ł—á–Ķ—Ā–ļ–į—Ź –ĺ–Ņ–Ķ—Ä–į—Ü–ł—Ź –Ņ—Ä–ĺ–≤–ĺ–ī–ł—ā—Ā—Ź –Ņ–ĺ–ī –ľ–ł–ļ—Ä–ĺ—Ā–ļ–ĺ–Ņ–ĺ–ľ, —á—ā–ĺ –Ņ–ĺ–∑–≤–ĺ–Ľ—Ź–Ķ—ā —Ā–ĺ—Ö—Ä–į–Ĺ–ł—ā—Ć —Ā–ĺ—Ā—É–ī—č –ł —ā–ļ–į–Ĺ–ł —Ź–ł—á–ļ–į. –ü—Ä–Ķ–ł–ľ—É—Č–Ķ—Ā—ā–≤–ĺ–ľ –Ľ–į–Ņ–į—Ä–ĺ—Ā–ļ–ĺ–Ņ–ł–ł —Ź–≤–Ľ—Ź–Ķ—ā—Ā—Ź –ľ–į–Ľ–į—Ź —ā—Ä–į–≤–ľ–į—ā–ł—á–Ĺ–ĺ—Ā—ā—Ć –ł –Ī—č—Ā—ā—Ä–ĺ–Ķ –≤–ĺ—Ā—Ā—ā–į–Ĺ–ĺ–≤–Ľ–Ķ–Ĺ–ł–Ķ.
‚ÄĘ –ú–ł–Ĺ–ł–ľ–į–Ľ—Ć–Ĺ—č–Ķ —Ä–į–∑—Ä–Ķ–∑—č –ł –Ī—č—Ā—ā—Ä–ĺ–Ķ –∑–į–∂–ł–≤–Ľ–Ķ–Ĺ–ł–Ķ
‚ÄĘ –ě—ā—Ā—É—ā—Ā—ā–≤–ł–Ķ –≥—Ä—É–Ī—č—Ö —Ä—É–Ī—Ü–ĺ–≤
‚ÄĘ –°–Ĺ–ł–∂–Ķ–Ĺ–ł–Ķ —Ä–ł—Ā–ļ–į –ĺ—Ā–Ľ–ĺ–∂–Ĺ–Ķ–Ĺ–ł–Ļ
–ü–ĺ—Ā–Ľ–Ķ–ĺ–Ņ–Ķ—Ä–į—Ü–ł–ĺ–Ĺ–Ĺ—č–Ļ –Ņ–Ķ—Ä–ł–ĺ–ī –Ņ—Ä–ĺ—Ö–ĺ–ī–ł—ā –Ľ–Ķ–≥–ļ–ĺ, –Ņ–į—Ü–ł–Ķ–Ĺ—ā –≤–ĺ–∑–≤—Ä–į—Č–į–Ķ—ā—Ā—Ź –ļ –ĺ–Ī—č—á–Ĺ–ĺ–Ļ –∂–ł–∑–Ĺ–ł —É–∂–Ķ —á–Ķ—Ä–Ķ–∑ –Ĺ–Ķ—Ā–ļ–ĺ–Ľ—Ć–ļ–ĺ –ī–Ĺ–Ķ–Ļ. –ö–ĺ–Ĺ—ā—Ä–ĺ–Ľ—Ć–Ĺ–ĺ–Ķ –£–ó–ė –Ņ—Ä–ĺ–≤–ĺ–ī–ł—ā—Ā—Ź —á–Ķ—Ä–Ķ–∑ 1‚Äď3 –ľ–Ķ—Ā—Ź—Ü–į –ī–Ľ—Ź –ĺ—Ü–Ķ–Ĺ–ļ–ł —ć—Ą—Ą–Ķ–ļ—ā–ł–≤–Ĺ–ĺ—Ā—ā–ł –Ľ–Ķ—á–Ķ–Ĺ–ł—Ź.
–ě–Ņ–Ķ—Ä–į—Ü–ł—Ź –Ņ–ĺ–Ľ–Ĺ–ĺ—Ā—ā—Ć—é —É—Ā—ā—Ä–į–Ĺ—Ź–Ķ—ā –Ņ–į—ā–ĺ–Ľ–ĺ–≥–ł—á–Ķ—Ā–ļ–ł–Ļ —Ä–Ķ—Ą–Ľ—é–ļ—Ā –ļ—Ä–ĺ–≤–ł, —É–Ľ—É—á—ą–į–Ķ—ā –Ņ–ł—ā–į–Ĺ–ł–Ķ —ā–ļ–į–Ĺ–Ķ–Ļ –ł –≤–ĺ—Ā—Ā—ā–į–Ĺ–į–≤–Ľ–ł–≤–į–Ķ—ā —Ą—É–Ĺ–ļ—Ü–ł—é —Ź–ł—á–ļ–į.
–ü–Ķ—Ä–ł–ĺ–ī –≤–ĺ—Ā—Ā—ā–į–Ĺ–ĺ–≤–Ľ–Ķ–Ĺ–ł—Ź –Ņ–ĺ—Ā–Ľ–Ķ –ĺ–Ņ–Ķ—Ä–į—Ü–ł–ł
–ü–ĺ—Ā–Ľ–Ķ —Ö–ł—Ä—É—Ä–≥–ł—á–Ķ—Ā–ļ–ĺ–≥–ĺ –≤–ľ–Ķ—ą–į—ā–Ķ–Ľ—Ć—Ā—ā–≤–į –≤–į–∂–Ĺ–ĺ —Ā–ĺ–Ī–Ľ—é–ī–į—ā—Ć —Ä–Ķ–ļ–ĺ–ľ–Ķ–Ĺ–ī–į—Ü–ł–ł –≤—Ä–į—á–į –ł –ł–∑–Ī–Ķ–≥–į—ā—Ć —Ą–ł–∑–ł—á–Ķ—Ā–ļ–ł—Ö –Ĺ–į–≥—Ä—É–∑–ĺ–ļ –≤ —ā–Ķ—á–Ķ–Ĺ–ł–Ķ –Ĺ–Ķ—Ā–ļ–ĺ–Ľ—Ć–ļ–ł—Ö –Ĺ–Ķ–ī–Ķ–Ľ—Ć. –ü–į—Ü–ł–Ķ–Ĺ—ā—É –Ĺ–į–∑–Ĺ–į—á–į—é—ā –Ņ—Ä–Ķ–Ņ–į—Ä–į—ā—č –ī–Ľ—Ź —É–Ľ—É—á—ą–Ķ–Ĺ–ł—Ź –ľ–ł–ļ—Ä–ĺ—Ü–ł—Ä–ļ—É–Ľ—Ź—Ü–ł–ł –ł –Ņ—Ä–ĺ—ā–ł–≤–ĺ–≤–ĺ—Ā–Ņ–į–Ľ–ł—ā–Ķ–Ľ—Ć–Ĺ—č–Ķ —Ā—Ä–Ķ–ī—Ā—ā–≤–į. –Ę–į–ļ–∂–Ķ –≤–į–∂–Ĺ–ĺ —Ā–ĺ–Ī–Ľ—é–ī–į—ā—Ć –≥–ł–≥–ł–Ķ–Ĺ—É –ł –Ĺ–Ķ –Ņ–Ķ—Ä–Ķ–≥—Ä–Ķ–≤–į—ā—Ć –ĺ–Ī–Ľ–į—Ā—ā—Ć –ľ–ĺ—ą–ĺ–Ĺ–ļ–ł.
–†–Ķ–į–Ī–ł–Ľ–ł—ā–į—Ü–ł—Ź –Ņ—Ä–ĺ—Ö–ĺ–ī–ł—ā –Ī—č—Ā—ā—Ä–ĺ, –ĺ—Ā–ĺ–Ī–Ķ–Ĺ–Ĺ–ĺ –Ņ–ĺ—Ā–Ľ–Ķ –ľ–ł–ļ—Ä–ĺ—Ö–ł—Ä—É—Ä–≥–ł—á–Ķ—Ā–ļ–ł—Ö –ł –Ľ–į–Ņ–į—Ä–ĺ—Ā–ļ–ĺ–Ņ–ł—á–Ķ—Ā–ļ–ł—Ö –≤–ľ–Ķ—ą–į—ā–Ķ–Ľ—Ć—Ā—ā–≤. –£–∂–Ķ —á–Ķ—Ä–Ķ–∑ 5‚Äď7 –ī–Ĺ–Ķ–Ļ –Ī–ĺ–Ľ—Ć—ą–ł–Ĺ—Ā—ā–≤–ĺ –ľ—É–∂—á–ł–Ĺ –ľ–ĺ–≥—É—ā –≤–Ķ—Ä–Ĺ—É—ā—Ć—Ā—Ź –ļ –Ņ–ĺ–≤—Ā–Ķ–ī–Ĺ–Ķ–≤–Ĺ—č–ľ –ī–Ķ–Ľ–į–ľ.
–†–Ķ–ļ–ĺ–ľ–Ķ–Ĺ–ī—É–Ķ—ā—Ā—Ź –≤—Ä–Ķ–ľ–Ķ–Ĺ–Ĺ–ĺ –ł—Ā–ļ–Ľ—é—á–ł—ā—Ć —Ā–Ņ–ĺ—Ä—ā, –Ņ–ĺ—Ā–Ķ—Č–Ķ–Ĺ–ł–Ķ –Ī–į–Ĺ—Ć –ł —Ā–į—É–Ĺ. –ß–Ķ—Ä–Ķ–∑ 1‚Äď2 –ľ–Ķ—Ā—Ź—Ü–į –Ņ—Ä–ĺ–≤–ĺ–ī–ł—ā—Ā—Ź –ļ–ĺ–Ĺ—ā—Ä–ĺ–Ľ—Ć–Ĺ–ĺ–Ķ –£–ó–ė –ł –į–Ĺ–į–Ľ–ł–∑ —Ā–Ņ–Ķ—Ä–ľ—č –ī–Ľ—Ź –Ņ–ĺ–ī—ā–≤–Ķ—Ä–∂–ī–Ķ–Ĺ–ł—Ź –≤–ĺ—Ā—Ā—ā–į–Ĺ–ĺ–≤–Ľ–Ķ–Ĺ–ł—Ź —Ą—É–Ĺ–ļ—Ü–ł–Ļ.
–ö–ĺ–ľ–Ņ–Ľ–Ķ–ļ—Ā–Ĺ–ĺ–Ķ —Ā–ĺ–Ī–Ľ—é–ī–Ķ–Ĺ–ł–Ķ —Ä–Ķ–ļ–ĺ–ľ–Ķ–Ĺ–ī–į—Ü–ł–Ļ –Ņ–ĺ–ľ–ĺ–≥–į–Ķ—ā –ł–∑–Ī–Ķ–∂–į—ā—Ć –ĺ—Ā–Ľ–ĺ–∂–Ĺ–Ķ–Ĺ–ł–Ļ –ł —É—Ā–ļ–ĺ—Ä—Ź–Ķ—ā –Ņ—Ä–ĺ—Ü–Ķ—Ā—Ā –∑–į–∂–ł–≤–Ľ–Ķ–Ĺ–ł—Ź.

–ü—Ä–ĺ—Ą–ł–Ľ–į–ļ—ā–ł–ļ–į —Ä–Ķ—Ü–ł–ī–ł–≤–ĺ–≤
–ü–ĺ—Ā–Ľ–Ķ —É—Ā–Ņ–Ķ—ą–Ĺ–ĺ–≥–ĺ –Ľ–Ķ—á–Ķ–Ĺ–ł—Ź –≤–į–∂–Ĺ–ĺ –Ņ—Ä–ĺ–≤–ĺ–ī–ł—ā—Ć –Ņ—Ä–ĺ—Ą–ł–Ľ–į–ļ—ā–ł–ļ—É –Ņ–ĺ–≤—ā–ĺ—Ä–Ĺ–ĺ–≥–ĺ —Ä–į—Ā—ą–ł—Ä–Ķ–Ĺ–ł—Ź –≤–Ķ–Ĺ. –≠—ā–ĺ –≤–ļ–Ľ—é—á–į–Ķ—ā —Ä–Ķ–≥—É–Ľ—Ź—Ä–Ĺ—č–Ķ –ĺ—Ā–ľ–ĺ—ā—Ä—č —É—Ä–ĺ–Ľ–ĺ–≥–į, –ļ–ĺ–Ĺ—ā—Ä–ĺ–Ľ—Ć –≤–Ķ—Ā–į –ł —Ą–ł–∑–ł—á–Ķ—Ā–ļ–ĺ–Ļ –į–ļ—ā–ł–≤–Ĺ–ĺ—Ā—ā–ł. –ě—ā–ļ–į–∑ –ĺ—ā –ļ—É—Ä–Ķ–Ĺ–ł—Ź –ł –į–Ľ–ļ–ĺ–≥–ĺ–Ľ—Ź —ā–į–ļ–∂–Ķ –Ī–Ľ–į–≥–ĺ–Ņ—Ä–ł—Ź—ā–Ĺ–ĺ –≤–Ľ–ł—Ź–Ķ—ā –Ĺ–į —Ā–ĺ—Ā—ā–ĺ—Ź–Ĺ–ł–Ķ —Ā–ĺ—Ā—É–ī–ĺ–≤.
–Ē–Ľ—Ź –Ņ–ĺ–ī–ī–Ķ—Ä–∂–į–Ĺ–ł—Ź –∑–ī–ĺ—Ä–ĺ–≤—Ć—Ź —Ā–ĺ—Ā—É–ī–ł—Ā—ā–ĺ–Ļ —Ā–ł—Ā—ā–Ķ–ľ—č —Ä–Ķ–ļ–ĺ–ľ–Ķ–Ĺ–ī—É–Ķ—ā—Ā—Ź:
‚ÄĘ –†–Ķ–≥—É–Ľ—Ź—Ä–Ĺ–į—Ź —É–ľ–Ķ—Ä–Ķ–Ĺ–Ĺ–į—Ź —Ą–ł–∑–ł—á–Ķ—Ā–ļ–į—Ź –į–ļ—ā–ł–≤–Ĺ–ĺ—Ā—ā—Ć
‚ÄĘ –ü—Ä–į–≤–ł–Ľ—Ć–Ĺ–ĺ–Ķ –Ņ–ł—ā–į–Ĺ–ł–Ķ –ł –≤–ĺ–ī–Ĺ—č–Ļ –Ī–į–Ľ–į–Ĺ—Ā
‚ÄĘ –ė–∑–Ī–Ķ–≥–į–Ĺ–ł–Ķ –Ņ–Ķ—Ä–Ķ–≥—Ä–Ķ–≤–į –ľ–ĺ—ą–ĺ–Ĺ–ļ–ł –ł —ā–Ķ—Ā–Ĺ–ĺ–≥–ĺ –Ī–Ķ–Ľ—Ć—Ź
–ö–ĺ–Ĺ—ā—Ä–ĺ–Ľ—Ć–Ĺ–ĺ–Ķ –ĺ–Ī—Ā–Ľ–Ķ–ī–ĺ–≤–į–Ĺ–ł–Ķ –Ņ–ĺ–∑–≤–ĺ–Ľ—Ź–Ķ—ā –≤–ĺ–≤—Ä–Ķ–ľ—Ź –≤—č—Ź–≤–ł—ā—Ć –≤–ĺ–∑–ľ–ĺ–∂–Ĺ—č–Ķ –ł–∑–ľ–Ķ–Ĺ–Ķ–Ĺ–ł—Ź –ł —Ā–ļ–ĺ—Ä—Ä–Ķ–ļ—ā–ł—Ä–ĺ–≤–į—ā—Ć –ĺ–Ī—Ä–į–∑ –∂–ł–∑–Ĺ–ł.
–°–Ľ–Ķ–ī–ĺ–≤–į–Ĺ–ł–Ķ —Ä–Ķ–ļ–ĺ–ľ–Ķ–Ĺ–ī–į—Ü–ł—Ź–ľ –≤—Ä–į—á–į –ł –∑–ī–ĺ—Ä–ĺ–≤—č–Ļ –ĺ–Ī—Ä–į–∑ –∂–ł–∑–Ĺ–ł ‚ÄĒ –Ľ—É—á—ą–ł–Ļ —Ā–Ņ–ĺ—Ā–ĺ–Ī —Ā–ĺ—Ö—Ä–į–Ĺ–ł—ā—Ć —Ä–Ķ–∑—É–Ľ—Ć—ā–į—ā –Ľ–Ķ—á–Ķ–Ĺ–ł—Ź –Ĺ–į –ī–ĺ–Ľ–≥–ł–Ķ –≥–ĺ–ī—č.
–í–Ľ–ł—Ź–Ĺ–ł–Ķ –≤–į—Ä–ł–ļ–ĺ—Ü–Ķ–Ľ–Ķ –Ĺ–į —Ą–Ķ—Ä—ā–ł–Ľ—Ć–Ĺ–ĺ—Ā—ā—Ć
–ě–ī–Ĺ–ł–ľ –ł–∑ –Ĺ–į–ł–Ī–ĺ–Ľ–Ķ–Ķ —Ā–Ķ—Ä—Ć—Ď–∑–Ĺ—č—Ö –Ņ–ĺ—Ā–Ľ–Ķ–ī—Ā—ā–≤–ł–Ļ –≤–į—Ä–ł–ļ–ĺ—Ü–Ķ–Ľ–Ķ —Ź–≤–Ľ—Ź–Ķ—ā—Ā—Ź –Ĺ–į—Ä—É—ą–Ķ–Ĺ–ł–Ķ —Ā–Ņ–Ķ—Ä–ľ–į—ā–ĺ–≥–Ķ–Ĺ–Ķ–∑–į. –ü–ĺ–≤—č—ą–Ķ–Ĺ–ł–Ķ —ā–Ķ–ľ–Ņ–Ķ—Ä–į—ā—É—Ä—č –≤ —Ź–ł—á–ļ–Ķ —É—Ö—É–ī—ą–į–Ķ—ā –ļ–į—á–Ķ—Ā—ā–≤–ĺ —Ā–Ņ–Ķ—Ä–ľ—č, —Ā–Ĺ–ł–∂–į–Ķ—ā –Ņ–ĺ–ī–≤–ł–∂–Ĺ–ĺ—Ā—ā—Ć —Ā–Ņ–Ķ—Ä–ľ–į—ā–ĺ–∑–ĺ–ł–ī–ĺ–≤ –ł –ľ–ĺ–∂–Ķ—ā –Ņ—Ä–ł–≤–Ķ—Ā—ā–ł –ļ –Ī–Ķ—Ā–Ņ–Ľ–ĺ–ī–ł—é. –ü—Ä–ł —ć—ā–ĺ–ľ –ī–į–∂–Ķ –Ņ–ĺ—Ā–Ľ–Ķ —É—Ā–Ņ–Ķ—ą–Ĺ–ĺ–≥–ĺ –Ľ–Ķ—á–Ķ–Ĺ–ł—Ź –Ņ–ĺ–ļ–į–∑–į—ā–Ķ–Ľ–ł —Ā–Ņ–Ķ—Ä–ľ—č –Ņ–ĺ—Ā—ā–Ķ–Ņ–Ķ–Ĺ–Ĺ–ĺ —É–Ľ—É—á—ą–į—é—ā—Ā—Ź.
–ü–į—Ü–ł–Ķ–Ĺ—ā–į–ľ, –Ņ–Ľ–į–Ĺ–ł—Ä—É—é—Č–ł–ľ –ĺ—ā—Ü–ĺ–≤—Ā—ā–≤–ĺ, –Ĺ–į–∑–Ĺ–į—á–į—é—ā —Ā–Ņ–Ķ—Ä–ľ–ĺ–≥—Ä–į–ľ–ľ—É –ī–ĺ –ł –Ņ–ĺ—Ā–Ľ–Ķ –ĺ–Ņ–Ķ—Ä–į—Ü–ł–ł –ī–Ľ—Ź –ĺ—Ü–Ķ–Ĺ–ļ–ł –ī–ł–Ĺ–į–ľ–ł–ļ–ł. –ü—Ä–ł –Ĺ–Ķ–ĺ–Ī—Ö–ĺ–ī–ł–ľ–ĺ—Ā—ā–ł –≤—Ä–į—á –Ĺ–į–∑–Ĺ–į—á–į–Ķ—ā –≤–ł—ā–į–ľ–ł–Ĺ–ĺ—ā–Ķ—Ä–į–Ņ–ł—é –ł –į–Ĺ—ā–ł–ĺ–ļ—Ā–ł–ī–į–Ĺ—ā—č.
–ü–ĺ—Ā–Ľ–Ķ –≤–ĺ—Ā—Ā—ā–į–Ĺ–ĺ–≤–Ľ–Ķ–Ĺ–ł—Ź –ļ—Ä–ĺ–≤–ĺ–ĺ–Ī—Ä–į—Č–Ķ–Ĺ–ł—Ź –Ĺ–ĺ—Ä–ľ–į–Ľ–ł–∑—É–Ķ—ā—Ā—Ź —ā–Ķ–ľ–Ņ–Ķ—Ä–į—ā—É—Ä–į —Ź–ł—á–ļ–į, —É–Ľ—É—á—ą–į–Ķ—ā—Ā—Ź –Ņ–ł—ā–į–Ĺ–ł–Ķ —ā–ļ–į–Ĺ–Ķ–Ļ, –ł —Ą–Ķ—Ä—ā–ł–Ľ—Ć–Ĺ–ĺ—Ā—ā—Ć –Ņ–ĺ—Ā—ā–Ķ–Ņ–Ķ–Ĺ–Ĺ–ĺ –≤–ĺ–∑–≤—Ä–į—Č–į–Ķ—ā—Ā—Ź.
–Ď–ĺ–Ľ—Ć—ą–ł–Ĺ—Ā—ā–≤–ĺ –Ņ–į—Ü–ł–Ķ–Ĺ—ā–ĺ–≤ –ĺ—ā–ľ–Ķ—á–į—é—ā —É–Ľ—É—á—ą–Ķ–Ĺ–ł–Ķ –Ņ–ĺ–ļ–į–∑–į—ā–Ķ–Ľ–Ķ–Ļ —É–∂–Ķ —á–Ķ—Ä–Ķ–∑ 3‚Äď6 –ľ–Ķ—Ā—Ź—Ü–Ķ–≤ –Ņ–ĺ—Ā–Ľ–Ķ –Ľ–Ķ—á–Ķ–Ĺ–ł—Ź.

–°–ĺ–≤—Ä–Ķ–ľ–Ķ–Ĺ–Ĺ—č–Ķ –ľ–Ķ—ā–ĺ–ī–ł–ļ–ł –Ľ–Ķ—á–Ķ–Ĺ–ł—Ź
–í –ļ–Ľ–ł–Ĺ–ł–ļ–Ķ –Ņ—Ä–ł–ľ–Ķ–Ĺ—Ź—é—ā—Ā—Ź –ł–Ĺ–Ĺ–ĺ–≤–į—Ü–ł–ĺ–Ĺ–Ĺ—č–Ķ –ľ–Ķ—ā–ĺ–ī—č –Ľ–Ķ—á–Ķ–Ĺ–ł—Ź –≤–į—Ä–ł–ļ–ĺ—Ü–Ķ–Ľ–Ķ, –ĺ–Ī–Ķ—Ā–Ņ–Ķ—á–ł–≤–į—é—Č–ł–Ķ —ā–ĺ—á–Ĺ–ĺ—Ā—ā—Ć –ł –Ī–Ķ–∑–ĺ–Ņ–į—Ā–Ĺ–ĺ—Ā—ā—Ć –≤–ľ–Ķ—ą–į—ā–Ķ–Ľ—Ć—Ā—ā–≤–į. –ú–ł–ļ—Ä–ĺ—Ö–ł—Ä—É—Ä–≥–ł—á–Ķ—Ā–ļ–į—Ź –ł —ć–Ĺ–ī–ĺ–≤–į—Ā–ļ—É–Ľ—Ź—Ä–Ĺ–į—Ź —ā–Ķ—Ö–Ĺ–ł–ļ–ł –Ņ–ĺ–∑–≤–ĺ–Ľ—Ź—é—ā —É—Ā—ā—Ä–į–Ĺ–ł—ā—Ć –∑–į–Ī–ĺ–Ľ–Ķ–≤–į–Ĺ–ł–Ķ –Ī–Ķ–∑ —Ä–ł—Ā–ļ–į –Ņ–ĺ–≤—Ä–Ķ–∂–ī–Ķ–Ĺ–ł—Ź –∑–ī–ĺ—Ä–ĺ–≤—č—Ö —Ā–ĺ—Ā—É–ī–ĺ–≤.
–ü—Ä–Ķ–ł–ľ—É—Č–Ķ—Ā—ā–≤–į —Ā–ĺ–≤—Ä–Ķ–ľ–Ķ–Ĺ–Ĺ—č—Ö –ľ–Ķ—ā–ĺ–ī–ł–ļ –≤–ļ–Ľ—é—á–į—é—ā:
‚ÄĘ –ú–ł–Ĺ–ł–ľ–į–Ľ—Ć–Ĺ–ĺ–Ķ –≤–ľ–Ķ—ą–į—ā–Ķ–Ľ—Ć—Ā—ā–≤–ĺ –≤ –ĺ—Ä–≥–į–Ĺ–ł–∑–ľ
‚ÄĘ –Ď—č—Ā—ā—Ä–ĺ–Ķ –≤–ĺ—Ā—Ā—ā–į–Ĺ–ĺ–≤–Ľ–Ķ–Ĺ–ł–Ķ
‚ÄĘ –í—č—Ā–ĺ–ļ—É—é —ć—Ą—Ą–Ķ–ļ—ā–ł–≤–Ĺ–ĺ—Ā—ā—Ć –ł –Ĺ–ł–∑–ļ–ł–Ļ —Ä–ł—Ā–ļ —Ä–Ķ—Ü–ł–ī–ł–≤–ĺ–≤
–í—Ā–Ķ –Ņ—Ä–ĺ—Ü–Ķ–ī—É—Ä—č –Ņ—Ä–ĺ–≤–ĺ–ī—Ź—ā—Ā—Ź –Ņ–ĺ–ī –ļ–ĺ–Ĺ—ā—Ä–ĺ–Ľ–Ķ–ľ –ĺ–Ņ—č—ā–Ĺ—č—Ö —É—Ä–ĺ–Ľ–ĺ–≥–ĺ–≤ —Ā –ł—Ā–Ņ–ĺ–Ľ—Ć–∑–ĺ–≤–į–Ĺ–ł–Ķ–ľ —Ā–ĺ–≤—Ä–Ķ–ľ–Ķ–Ĺ–Ĺ–ĺ–≥–ĺ –ĺ–Ī–ĺ—Ä—É–ī–ĺ–≤–į–Ĺ–ł—Ź.
–ü–į—Ü–ł–Ķ–Ĺ—ā—č –Ī—č—Ā—ā—Ä–ĺ –≤–ĺ–∑–≤—Ä–į—Č–į—é—ā—Ā—Ź –ļ –Ņ—Ä–ł–≤—č—á–Ĺ–ĺ–Ļ –∂–ł–∑–Ĺ–ł, —Ā–ĺ—Ö—Ä–į–Ĺ—Ź—Ź —Ä–Ķ–Ņ—Ä–ĺ–ī—É–ļ—ā–ł–≤–Ĺ—É—é —Ą—É–Ĺ–ļ—Ü–ł—é –ł –∑–ī–ĺ—Ä–ĺ–≤—Ć–Ķ.
–ö–ĺ–≥–ī–į –Ĺ—É–∂–Ĺ–ĺ –ĺ–Ī—Ä–į—Č–į—ā—Ć—Ā—Ź –ļ –≤—Ä–į—á—É
–ü—Ä–ł –Ņ–Ķ—Ä–≤—č—Ö –Ņ—Ä–ł–∑–Ĺ–į–ļ–į—Ö –ī–ł—Ā–ļ–ĺ–ľ—Ą–ĺ—Ä—ā–į –≤ –ľ–ĺ—ą–ĺ–Ĺ–ļ–Ķ, —ā—Ź–∂–Ķ—Ā—ā–ł –ł–Ľ–ł –į—Ā–ł–ľ–ľ–Ķ—ā—Ä–ł–ł —Ā–Ľ–Ķ–ī—É–Ķ—ā –∑–į–Ņ–ł—Ā–į—ā—Ć—Ā—Ź –ļ —É—Ä–ĺ–Ľ–ĺ–≥—É. –ó–į–ī–Ķ—Ä–∂–ļ–į —Ā –ĺ–Ī—Ä–į—Č–Ķ–Ĺ–ł–Ķ–ľ –ľ–ĺ–∂–Ķ—ā –Ņ—Ä–ł–≤–Ķ—Ā—ā–ł –ļ —É—Ö—É–ī—ą–Ķ–Ĺ–ł—é —Ą—É–Ĺ–ļ—Ü–ł–ł —Ź–ł—á–Ķ–ļ –ł –Ņ—Ä–ĺ–Ī–Ľ–Ķ–ľ–į–ľ —Ā —Ą–Ķ—Ä—ā–ł–Ľ—Ć–Ĺ–ĺ—Ā—ā—Ć—é. –ß–Ķ–ľ —Ä–į–Ĺ—Ć—ą–Ķ –≤—č—Ź–≤–Ľ–Ķ–Ĺ–ĺ –∑–į–Ī–ĺ–Ľ–Ķ–≤–į–Ĺ–ł–Ķ, —ā–Ķ–ľ —ć—Ą—Ą–Ķ–ļ—ā–ł–≤–Ĺ–Ķ–Ķ –Ľ–Ķ—á–Ķ–Ĺ–ł–Ķ.
–Ě–Ķ–Ľ—Ć–∑—Ź –ł–≥–Ĺ–ĺ—Ä–ł—Ä–ĺ–≤–į—ā—Ć –ī–į–∂–Ķ –Ľ—Ď–≥–ļ–ł–Ķ —ā—Ź–Ĺ—É—Č–ł–Ķ –Ī–ĺ–Ľ–ł ‚ÄĒ —ć—ā–ĺ –ľ–ĺ–∂–Ķ—ā –Ī—č—ā—Ć –Ņ—Ä–ł–∑–Ĺ–į–ļ–ĺ–ľ –Ĺ–į—á–į–Ľ—Ć–Ĺ–ĺ–Ļ —Ā—ā–į–ī–ł–ł –≤–į—Ä–ł–ļ–ĺ—Ü–Ķ–Ľ–Ķ. –í—Ä–į—á –Ņ—Ä–ĺ–≤–Ķ–ī—Ď—ā –ĺ–Ī—Ā–Ľ–Ķ–ī–ĺ–≤–į–Ĺ–ł–Ķ –ł –Ņ–ĺ–ī–Ī–Ķ—Ä—Ď—ā –Ī–Ķ–∑–ĺ–Ņ–į—Ā–Ĺ–ĺ–Ķ –Ľ–Ķ—á–Ķ–Ĺ–ł–Ķ.
–°–≤–ĺ–Ķ–≤—Ä–Ķ–ľ–Ķ–Ĺ–Ĺ–ĺ–Ķ –ĺ–Ī—Ä–į—Č–Ķ–Ĺ–ł–Ķ –Ņ–ĺ–∑–≤–ĺ–Ľ—Ź–Ķ—ā –ł–∑–Ī–Ķ–∂–į—ā—Ć –ĺ–Ņ–Ķ—Ä–į—Ü–ł–ł –ł —Ā–ĺ—Ö—Ä–į–Ĺ–ł—ā—Ć –∑–ī–ĺ—Ä–ĺ–≤—Ć–Ķ —Ä–Ķ–Ņ—Ä–ĺ–ī—É–ļ—ā–ł–≤–Ĺ–ĺ–Ļ —Ā–ł—Ā—ā–Ķ–ľ—č.
–Ē–į–∂–Ķ –Ņ—Ä–ł –ĺ—ā—Ā—É—ā—Ā—ā–≤–ł–ł —Ā–ł–ľ–Ņ—ā–ĺ–ľ–ĺ–≤ –ľ—É–∂—á–ł–Ĺ–į–ľ —Ä–Ķ–ļ–ĺ–ľ–Ķ–Ĺ–ī—É–Ķ—ā—Ā—Ź –Ņ—Ä–ĺ—Ö–ĺ–ī–ł—ā—Ć –Ņ—Ä–ĺ—Ą–ł–Ľ–į–ļ—ā–ł—á–Ķ—Ā–ļ–ł–Ķ –ĺ—Ā–ľ–ĺ—ā—Ä—č —Ä–į–∑ –≤ –≥–ĺ–ī.

–í–ĺ–∑–ľ–ĺ–∂–Ĺ—č–Ķ –ĺ—Ā–Ľ–ĺ–∂–Ĺ–Ķ–Ĺ–ł—Ź –Ņ—Ä–ł –ĺ—ā—Ā—É—ā—Ā—ā–≤–ł–ł –Ľ–Ķ—á–Ķ–Ĺ–ł—Ź
–ē—Ā–Ľ–ł –≤–į—Ä–ł–ļ–ĺ—Ü–Ķ–Ľ–Ķ –Ĺ–Ķ –Ľ–Ķ—á–ł—ā—Ć, –ĺ–Ĺ–ĺ –ľ–ĺ–∂–Ķ—ā –Ņ—Ä–ł–≤–Ķ—Ā—ā–ł –ļ –į—ā—Ä–ĺ—Ą–ł–ł —Ź–ł—á–ļ–į, —Ā–Ĺ–ł–∂–Ķ–Ĺ–ł—é –≤—č—Ä–į–Ī–ĺ—ā–ļ–ł —ā–Ķ—Ā—ā–ĺ—Ā—ā–Ķ—Ä–ĺ–Ĺ–į –ł –Ī–Ķ—Ā–Ņ–Ľ–ĺ–ī–ł—é. –ü–ĺ—Ā—ā–Ķ–Ņ–Ķ–Ĺ–Ĺ–ĺ –Ĺ–į—Ä—É—ą–į–Ķ—ā—Ā—Ź –Ņ–ł—ā–į–Ĺ–ł–Ķ —ā–ļ–į–Ĺ–Ķ–Ļ, –ł –ĺ—Ä–≥–į–Ĺ —ā–Ķ—Ä—Ź–Ķ—ā —Ā–≤–ĺ–ł —Ą—É–Ĺ–ļ—Ü–ł–ł. –í —ā—Ź–∂—Ď–Ľ—č—Ö —Ā–Ľ—É—á–į—Ź—Ö —Ä–į–∑–≤–ł–≤–į–Ķ—ā—Ā—Ź –≤–ĺ—Ā–Ņ–į–Ľ–Ķ–Ĺ–ł–Ķ –ł —Ö—Ä–ĺ–Ĺ–ł—á–Ķ—Ā–ļ–į—Ź –Ī–ĺ–Ľ—Ć.
–†–ł—Ā–ļ –ĺ—Ā–Ľ–ĺ–∂–Ĺ–Ķ–Ĺ–ł–Ļ –≤–ĺ–∑—Ä–į—Ā—ā–į–Ķ—ā –Ņ—Ä–ł —Ą–ł–∑–ł—á–Ķ—Ā–ļ–ł—Ö –Ĺ–į–≥—Ä—É–∑–ļ–į—Ö –ł –Ĺ–Ķ—Ā–ĺ–Ī–Ľ—é–ī–Ķ–Ĺ–ł–ł —Ä–Ķ–ļ–ĺ–ľ–Ķ–Ĺ–ī–į—Ü–ł–Ļ –≤—Ä–į—á–į.
–Ē–į–∂–Ķ –Ņ–ĺ—Ā–Ľ–Ķ —Ö–ł—Ä—É—Ä–≥–ł—á–Ķ—Ā–ļ–ĺ–≥–ĺ –Ľ–Ķ—á–Ķ–Ĺ–ł—Ź –≤–į–∂–Ĺ–ĺ –ļ–ĺ–Ĺ—ā—Ä–ĺ–Ľ–ł—Ä–ĺ–≤–į—ā—Ć —Ā–ĺ—Ā—ā–ĺ—Ź–Ĺ–ł–Ķ –≤–Ķ–Ĺ, –ĺ—Ā–ĺ–Ī–Ķ–Ĺ–Ĺ–ĺ –Ņ—Ä–ł —Ā–ļ–Ľ–ĺ–Ĺ–Ĺ–ĺ—Ā—ā–ł –ļ –≤–į—Ä–ł–ļ–ĺ–∑—É.
–†–Ķ–≥—É–Ľ—Ź—Ä–Ĺ–ĺ–Ķ –Ĺ–į–Ī–Ľ—é–ī–Ķ–Ĺ–ł–Ķ –ł –ļ–ĺ–Ĺ—ā—Ä–ĺ–Ľ—Ć–Ĺ–ĺ–Ķ –£–ó–ė –Ņ–ĺ–∑–≤–ĺ–Ľ—Ź—é—ā –ł–∑–Ī–Ķ–∂–į—ā—Ć —Ä–Ķ—Ü–ł–ī–ł–≤–ĺ–≤ –ł —Ā–ĺ—Ö—Ä–į–Ĺ–ł—ā—Ć –∑–ī–ĺ—Ä–ĺ–≤—Ć–Ķ.
–ü—Ä–ĺ–≥–Ĺ–ĺ–∑ –ł —Ä–Ķ–∑—É–Ľ—Ć—ā–į—ā—č –Ľ–Ķ—á–Ķ–Ĺ–ł—Ź
–ü—Ä–ł —Ā–≤–ĺ–Ķ–≤—Ä–Ķ–ľ–Ķ–Ĺ–Ĺ–ĺ–ľ –Ľ–Ķ—á–Ķ–Ĺ–ł–ł –Ņ—Ä–ĺ–≥–Ĺ–ĺ–∑ –Ī–Ľ–į–≥–ĺ–Ņ—Ä–ł—Ź—ā–Ĺ—č–Ļ. –ü–ĺ—Ā–Ľ–Ķ –ĺ–Ņ–Ķ—Ä–į—Ü–ł–ł –ļ—Ä–ĺ–≤–ĺ—ā–ĺ–ļ –≤–ĺ—Ā—Ā—ā–į–Ĺ–į–≤–Ľ–ł–≤–į–Ķ—ā—Ā—Ź, –ł—Ā—á–Ķ–∑–į—é—ā –Ī–ĺ–Ľ–ł, –ł —É–Ľ—É—á—ą–į–Ķ—ā—Ā—Ź –ļ–į—á–Ķ—Ā—ā–≤–ĺ —Ā–Ņ–Ķ—Ä–ľ—č. –Ď–ĺ–Ľ—Ć—ą–ł–Ĺ—Ā—ā–≤–ĺ –ľ—É–∂—á–ł–Ĺ –≤–ĺ–∑–≤—Ä–į—Č–į—é—ā—Ā—Ź –ļ –į–ļ—ā–ł–≤–Ĺ–ĺ–Ļ –∂–ł–∑–Ĺ–ł –Ī–Ķ–∑ –ĺ–≥—Ä–į–Ĺ–ł—á–Ķ–Ĺ–ł–Ļ.
–ü–ĺ–Ľ–Ĺ–ĺ–Ķ –≤–ĺ—Ā—Ā—ā–į–Ĺ–ĺ–≤–Ľ–Ķ–Ĺ–ł–Ķ —Ą–Ķ—Ä—ā–ł–Ľ—Ć–Ĺ–ĺ—Ā—ā–ł –∑–į–Ĺ–ł–ľ–į–Ķ—ā –ĺ—ā —ā—Ä—Ď—Ö –ī–ĺ —ą–Ķ—Ā—ā–ł –ľ–Ķ—Ā—Ź—Ü–Ķ–≤, –Ņ–ĺ—Ā–Ľ–Ķ —á–Ķ–≥–ĺ –≤–ĺ–∑–ľ–ĺ–∂–Ĺ–ĺ –Ņ–Ľ–į–Ĺ–ł—Ä–ĺ–≤–į–Ĺ–ł–Ķ –Ī–Ķ—Ä–Ķ–ľ–Ķ–Ĺ–Ĺ–ĺ—Ā—ā–ł. –†–ł—Ā–ļ –Ņ–ĺ–≤—ā–ĺ—Ä–Ĺ–ĺ–≥–ĺ –≤–į—Ä–ł–ļ–ĺ—Ü–Ķ–Ľ–Ķ –ľ–ł–Ĺ–ł–ľ–į–Ľ–Ķ–Ĺ –Ņ—Ä–ł —Ā–ĺ–Ī–Ľ—é–ī–Ķ–Ĺ–ł–ł —Ä–Ķ–ļ–ĺ–ľ–Ķ–Ĺ–ī–į—Ü–ł–Ļ –≤—Ä–į—á–į.
–°–ĺ–≤—Ä–Ķ–ľ–Ķ–Ĺ–Ĺ—č–Ķ —ā–Ķ—Ö–Ĺ–ĺ–Ľ–ĺ–≥–ł–ł –Ņ–ĺ–∑–≤–ĺ–Ľ—Ź—é—ā –Ņ—Ä–ĺ–≤–ĺ–ī–ł—ā—Ć –ĺ–Ņ–Ķ—Ä–į—Ü–ł–ł —Ā –ľ–ł–Ĺ–ł–ľ–į–Ľ—Ć–Ĺ—č–ľ —Ä–ł—Ā–ļ–ĺ–ľ, —á—ā–ĺ –ī–Ķ–Ľ–į–Ķ—ā –Ľ–Ķ—á–Ķ–Ĺ–ł–Ķ –ľ–į–ļ—Ā–ł–ľ–į–Ľ—Ć–Ĺ–ĺ –Ī–Ķ–∑–ĺ–Ņ–į—Ā–Ĺ—č–ľ.
–Ē–ĺ–Ľ–≥–ĺ—Ā—Ä–ĺ—á–Ĺ—č–Ķ —Ä–Ķ–∑—É–Ľ—Ć—ā–į—ā—č –Ņ–ĺ–ļ–į–∑—č–≤–į—é—ā –≤—č—Ā–ĺ–ļ—É—é —ć—Ą—Ą–Ķ–ļ—ā–ł–≤–Ĺ–ĺ—Ā—ā—Ć —ā–Ķ—Ä–į–Ņ–ł–ł –Ņ—Ä–ł –ĺ–Ī—Ä–į—Č–Ķ–Ĺ–ł–ł –Ĺ–į —Ä–į–Ĺ–Ĺ–Ķ–Ļ —Ā—ā–į–ī–ł–ł.

–ü–ĺ—á–Ķ–ľ—É –≤—č–Ī–ł—Ä–į—é—ā –ļ–Ľ–ł–Ĺ–ł–ļ—É "–Ė–ł–∑–Ĺ—Ć-–ě–Ņ–ĺ—Ä–į"
–ö–Ľ–ł–Ĺ–ł–ļ–į ¬ę–Ė–ł–∑–Ĺ—Ć-–ě–Ņ–ĺ—Ä–į¬Ľ —Ā–Ņ–Ķ—Ü–ł–į–Ľ–ł–∑–ł—Ä—É–Ķ—ā—Ā—Ź –Ĺ–į –Ľ–Ķ—á–Ķ–Ĺ–ł–ł –ľ—É–∂—Ā–ļ–ł—Ö –∑–į–Ī–ĺ–Ľ–Ķ–≤–į–Ĺ–ł–Ļ, –≤–ļ–Ľ—é—á–į—Ź –≤–į—Ä–ł–ļ–ĺ—Ü–Ķ–Ľ–Ķ –≤—Ā–Ķ—Ö —Ā—ā–Ķ–Ņ–Ķ–Ĺ–Ķ–Ļ. –ó–ī–Ķ—Ā—Ć —Ä–į–Ī–ĺ—ā–į—é—ā –ĺ–Ņ—č—ā–Ĺ—č–Ķ —É—Ä–ĺ–Ľ–ĺ–≥–ł, –Ņ—Ä–ł–ľ–Ķ–Ĺ—Ź—é—Č–ł–Ķ –Ĺ–ĺ–≤–Ķ–Ļ—ą–ł–Ķ –ľ–Ķ—ā–ĺ–ī—č –ī–ł–į–≥–Ĺ–ĺ—Ā—ā–ł–ļ–ł –ł —Ö–ł—Ä—É—Ä–≥–ł–ł. –í—Ā–Ķ –Ņ—Ä–ĺ—Ü–Ķ–ī—É—Ä—č –Ņ—Ä–ĺ–≤–ĺ–ī—Ź—ā—Ā—Ź –≤ –ļ–ĺ–ľ—Ą–ĺ—Ä—ā–Ĺ—č—Ö —É—Ā–Ľ–ĺ–≤–ł—Ź—Ö, —Ā –ł–Ĺ–ī–ł–≤–ł–ī—É–į–Ľ—Ć–Ĺ—č–ľ –Ņ–ĺ–ī—Ö–ĺ–ī–ĺ–ľ –ļ –ļ–į–∂–ī–ĺ–ľ—É –Ņ–į—Ü–ł–Ķ–Ĺ—ā—É.
–ü–į—Ü–ł–Ķ–Ĺ—ā—č –Ņ–ĺ–Ľ—É—á–į—é—ā –Ņ–ĺ–Ľ–Ĺ–ĺ–Ķ —Ā–ĺ–Ņ—Ä–ĺ–≤–ĺ–∂–ī–Ķ–Ĺ–ł–Ķ ‚ÄĒ –ĺ—ā –ļ–ĺ–Ĺ—Ā—É–Ľ—Ć—ā–į—Ü–ł–ł –ī–ĺ –Ņ–ĺ—Ā–Ľ–Ķ–ĺ–Ņ–Ķ—Ä–į—Ü–ł–ĺ–Ĺ–Ĺ–ĺ–≥–ĺ –Ĺ–į–Ī–Ľ—é–ī–Ķ–Ĺ–ł—Ź. –ü—Ä–ł–ľ–Ķ–Ĺ—Ź—é—ā—Ā—Ź —ā–ĺ–Ľ—Ć–ļ–ĺ –Ņ—Ä–ĺ–≤–Ķ—Ä–Ķ–Ĺ–Ĺ—č–Ķ —ā–Ķ—Ö–Ĺ–ĺ–Ľ–ĺ–≥–ł–ł, –ĺ–Ī–Ķ—Ā–Ņ–Ķ—á–ł–≤–į—é—Č–ł–Ķ –Ī—č—Ā—ā—Ä–ĺ–Ķ –≤–ĺ—Ā—Ā—ā–į–Ĺ–ĺ–≤–Ľ–Ķ–Ĺ–ł–Ķ –ł –ī–ĺ–Ľ–≥–ĺ—Ā—Ä–ĺ—á–Ĺ—č–Ļ —Ä–Ķ–∑—É–Ľ—Ć—ā–į—ā.
–í—č—Ā–ĺ–ļ–ł–Ļ —É—Ä–ĺ–≤–Ķ–Ĺ—Ć —Ā–Ķ—Ä–≤–ł—Ā–į, —Ā–ĺ–≤—Ä–Ķ–ľ–Ķ–Ĺ–Ĺ–ĺ–Ķ –ĺ–Ī–ĺ—Ä—É–ī–ĺ–≤–į–Ĺ–ł–Ķ –ł –≤–Ĺ–ł–ľ–į—ā–Ķ–Ľ—Ć–Ĺ–ĺ–Ķ –ĺ—ā–Ĺ–ĺ—ą–Ķ–Ĺ–ł–Ķ –Ņ–Ķ—Ä—Ā–ĺ–Ĺ–į–Ľ–į –ī–Ķ–Ľ–į—é—ā –Ľ–Ķ—á–Ķ–Ĺ–ł–Ķ –ľ–į–ļ—Ā–ł–ľ–į–Ľ—Ć–Ĺ–ĺ —ć—Ą—Ą–Ķ–ļ—ā–ł–≤–Ĺ—č–ľ –ł –Ī–Ķ–∑–ĺ–Ņ–į—Ā–Ĺ—č–ľ.
–ė–ľ–Ķ–Ĺ–Ĺ–ĺ –Ņ–ĺ—ć—ā–ĺ–ľ—É –ľ—É–∂—á–ł–Ĺ—č –ī–ĺ–≤–Ķ—Ä—Ź—é—ā —Ā–≤–ĺ—Ď –∑–ī–ĺ—Ä–ĺ–≤—Ć–Ķ –ļ–Ľ–ł–Ĺ–ł–ļ–Ķ ¬ę–Ė–ł–∑–Ĺ—Ć-–ě–Ņ–ĺ—Ä–į¬Ľ, –≥–ī–Ķ —Ā–ĺ—á–Ķ—ā–į—é—ā—Ā—Ź –Ņ—Ä–ĺ—Ą–Ķ—Ā—Ā–ł–ĺ–Ĺ–į–Ľ–ł–∑–ľ, –∑–į–Ī–ĺ—ā–į –ł –≥–į—Ä–į–Ĺ—ā–ł—Ä–ĺ–≤–į–Ĺ–Ĺ—č–Ļ —Ä–Ķ–∑—É–Ľ—Ć—ā–į—ā.
–ü–ĺ—á–Ķ–ľ—É –≤—č–Ī–ł—Ä–į—é—ā –Ĺ–į—Ā?

–í–ĺ–Ņ—Ä–ĺ—Ā-–ĺ—ā–≤–Ķ—ā
–°—ā–į—ā—Ć–ł
–ě—ā–∑—č–≤—č
–ü–Ķ—Ä—Ā–ĺ–Ĺ–į–Ľ—Ć–Ĺ—č–Ķ –Ņ—Ä–Ķ–ī–Ľ–ĺ–∂–Ķ–Ĺ–ł—Ź –ī–Ľ—Ź –≤–į—Ā
–£—Ā–Ľ—É–≥–ł –Ĺ–į—ą–Ķ–Ļ –ļ–Ľ–ł–Ĺ–ł–ļ–ł





–ó–į—Ź–≤–ļ–į –Ņ—Ä–ł–Ĺ—Ź—ā–į
–ź–ī—Ä–Ķ—Ā –ļ–Ľ–ł–Ĺ–ł–ļ–ł
–°–Ī ‚Äď –í—Ā —Ā 9:00 –ī–ĺ 19:00
–°–Ī ‚Äď –í—Ā —Ā 9:00 –ī–ĺ 19:00








 –≥. –ē–ļ–į—ā–Ķ—Ä–ł–Ĺ–Ī—É—Ä–≥ —É–Ľ. –ģ–Ľ–ł—É—Ā–į –§—É—á–ł–ļ–į, 11
–≥. –ē–ļ–į—ā–Ķ—Ä–ł–Ĺ–Ī—É—Ä–≥ —É–Ľ. –ģ–Ľ–ł—É—Ā–į –§—É—á–ł–ļ–į, 11